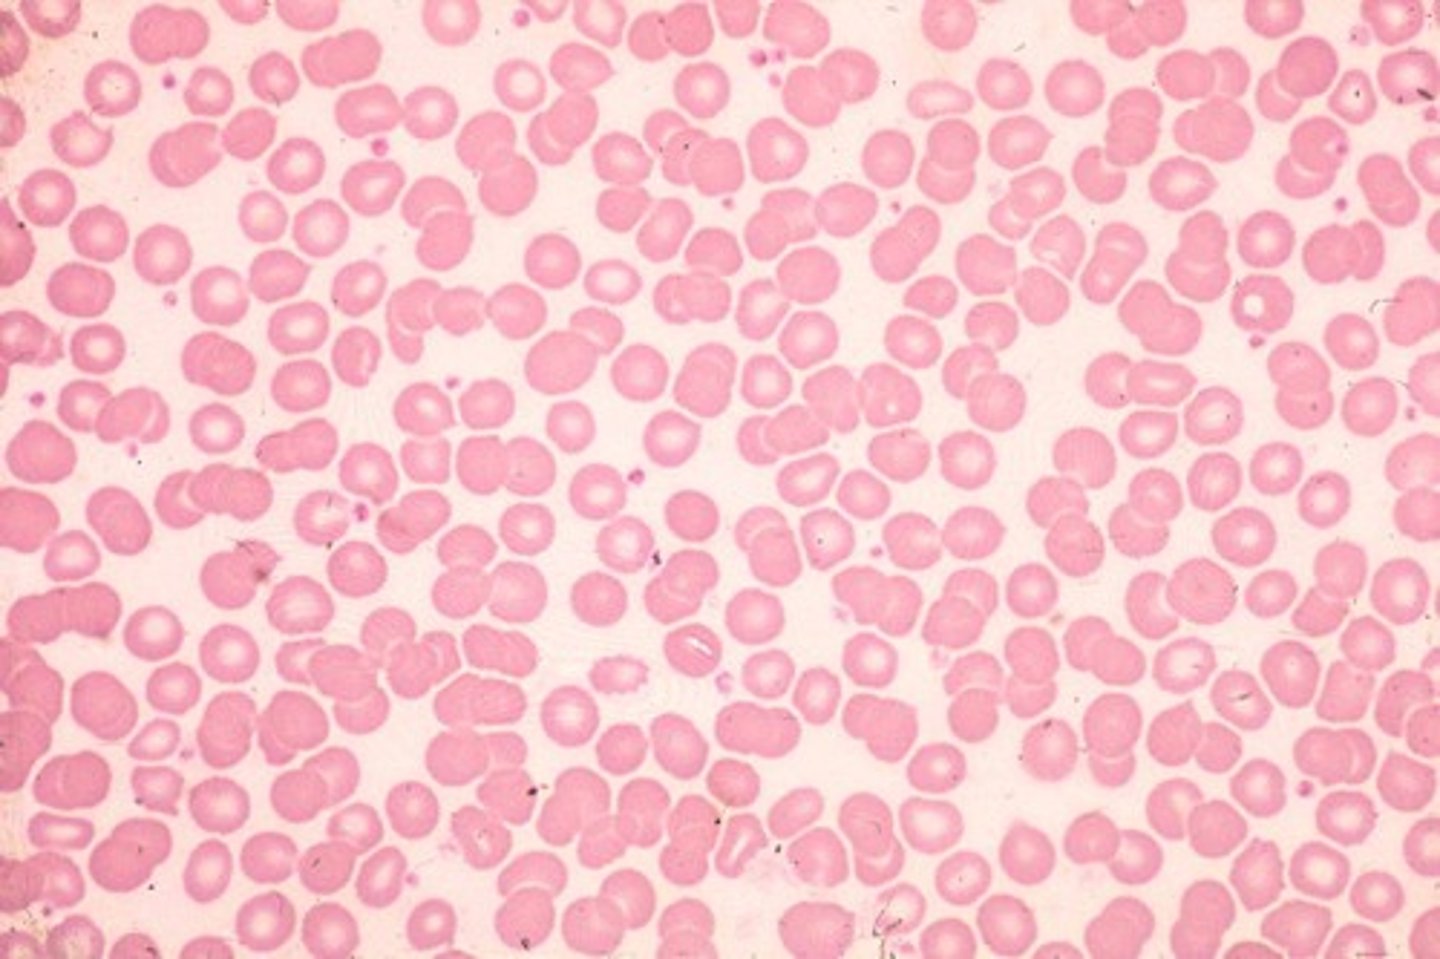
<p>normal size and color</p>

BIO 190 Lab #7- DNA and Blast
1/52
There's no tags or description
Looks like no tags are added yet.
Name | Mastery | Learn | Test | Matching | Spaced | Call with Kai |
|---|
No analytics yet
Send a link to your students to track their progress
53 Terms
DNA is composed of a double chain of 4 alternating ________
nucleotides
each nucleotide contains a ..
sugar, phosphate group, nitrogenous base

what are the 4 nitrogenous bases for DNA
Adenine, Thymine, Guanine, Cytosine
describe Watson and cricks work (know the year)
in 1953 they compiled all info known about DNA and published their proposed structure: a double helix with an outer sugar phosphate backbone and paired bases facing inwards
what did Rosalind Franklin do (year)
in 1953 she determined the spacial relationships of the backbone, that A form is antiparallel using X-rays to show structure of DNA
What did Alfred Hershey and Martha Chase do? (year)
1952, they used bacteriophages grown in radioactive medium to show that DNA enters the cells as transforming agents
what did Erwin Chargoff do (year)
(1949) found that the amount of adenine = thymine and guanine= cytosine
3 things that differentiate RNA from DNA
sugar, single strand, uracil
What did Frederick Griffith discover? (year)
1928, discovers that heat killed bacteria can transform a non virulent strain. genetic material is a heat stable chemical
what did Oswald Avery, McAllen McCarty and Collin McLeod identify (year)
1944 they identified griffths transforming agent as DNA
only DNA is capable of transforming the non virulent strain of bacteria
what did thomas hunt morgan do (year)
1915 used fruit flys to provide direct evidence is chromosome theory of inheritance
DNA replication
The process in which DNA makes a duplicate copy of itself.

where does DNA replication take place
in the nucleus during the S phase
what triggers DNA replication
enzymes
overview of the steps of DNA replication
1. replication begins when DNA is unwound and the two strands separate from each other along the hydrogen bonding pairs
2. each old strand is a template for the new bases and base pair rules are followed
3. 2 new strands are formed using information from the original parent strands. each molecule has an old parent strand and a new daughter strand = semiconservative
what is semiconservative replication
Each new helix contains a strand from the parent DNA molecule and a newly synthesized strand.
DNA holds the codes for the ___________ that builds a ____________
amino acids; protein
where does protein synthesis occur
the cytoplasm
the code from DNA is copied through the process of ___________ and the copy goes to the cytoplasm to be used to create proteins through ______________
transcription; translation
when the code on a strand of DNA is transcribed a strand of _______ is produced
mRNA
after transcription the mRNA moved out of the nucleus and into the _______
cytoplasm to the site of protein synthesis which are ribosomes
What is ribosomal RNA (rRNA)?
RNA that becomes part of ribosomes (the main component of ribosomes) and catalyzes the bonding of amino acids
what does tRNA do
picks up amino acids
each tRNA picks up a certain amino acid and moves it to the ribosome

a strand of mRNA is sub divied into____
codons
what did the lysis buffer do in the DNA lab
broke open the cells in our solution
what did protease do in the DNA lab?
digests other proteins in the cell
what did we need to place our test tube in the 50 celcius water bath for 10 minutes after adding protease
because protease is active at high temperatures
mutation
DNA code that has an error in it
sickle cell anemia
a genetic disorder that causes sickle shape in blood cells which can not pass along narrow capillaries. this causes poor circulation
(look for flat cells)

normal blood cells
normal size and color
How does transcription start
when transcription factors bind to enhancer elements which allow RNA polymerase to bind to the promotor
what is the G cap
- added to the 5' end of mature mRNA
- made of a modified guanine nucelotide with three phospates
- protects the mature mRNA from degradation in the cytoplasm

what is the poly A tail
-string of adenine nucleotides at the 3' end of mature mRNAs.
-aids in the export of mRNAs from the nucleus and causes the mRNA to be more stable and exist for longer
-has opposite effect in bacteria, causing the mRNA to degrade

introns vs exons
Exons contain the actual genetic information coding for protein.
Introns are intervening noncoding segments of DNA. ("IN trons stay IN the nucleus, whereas EX ons EX it and are EX pressed")

what does BLAST stand for
Basic Local Alignment Search Tool
what does BLAST do
finds regions of local similarity between sequences
how many nitrogenous bases are there
four

why are they called nitrogenous bases
because they contain nitrogen atoms, and "bases" due to their ability to act as proton acceptors, similar to the chemical behavior of a base
which 2 nucleotides are purines
Adenine and Guanine
which 2 nucleotides are pyrimidines
thymine and cytosine
purine vs pyrimidines
purine: A, G, two rings
pyrimidines: C, T, U, 1 ring
how many hydrogen bonds bind A-T together
2
steps of DNA replication, transcription, and translation
1. Initiation
2. Elongation
3. Termination
what triggers DNA replication
helicase unwinding
semiconservative replication
each new DNA molecule consists of one new strand and one old strand
describe translation
Process where the information carried by mRNA is used to produce proteins.
where does translation occur
cytoplasm / ribosome
are amino acids monomers or polymers
monomers
how are amino acids bound together to form proteins
peptide bonds
what is hemoglobin
A protein in red blood cells that carries oxygen.
what type of mutation was sickle cell anemia
point mutation in the beta-globin gene (HBB) on chromosome 11
what type of bond is between nitrogenous bases
hydrogen bonds

what type of bond is between nucleotides
phosphodiester bond
(the strong stable bond for structure around the backbone)
